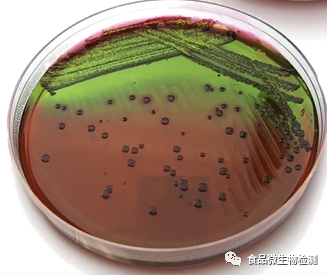
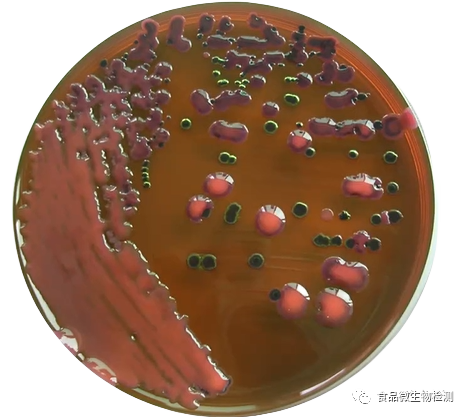

【学习笔记】GB 5749生活饮用水微生物指标——总大肠菌群
发布时间:2025-05-08 浏览次数:16966
GB5749-2022 规定的常规检验微生物指标共3项,总大肠菌群、大肠埃希氏菌、菌落总数。
其中水中菌落总数可作为评价水质清洁程度和考核净化效果;大肠菌群指示水体是否存在肠道传染病的可能性。
总大肠菌群主要包括4个菌属:埃希氏菌属、柠檬酸菌属、克雷伯菌属、肠杆菌属。这些菌属可以在人、畜粪便中检出,有的也可以在营养丰富的水体中检出,即在非粪便污染的情况下,也有检出这些细菌的可能性。耐热大肠菌群和总大肠菌群组成相同,但主要组成是埃希菌属,在此菌属中与人类生活密切相关的仅有一个种,即大肠埃希氏菌。柠檬酸菌属、克雷伯菌属和肠杆菌属所占数量较少。作为粪便污染的指示菌,大肠埃希氏菌检出的意义最大,其次是粪大肠菌群,总大肠菌群的卫生学意义稍逊一些。
PART.1 检测依据
1、GB/T 5750.2-2023《生活饮用水标准检验方法 第2部分:水样的采集与保存》
2、GB/T 5750.12-2023《生活饮用水标准检验方法 第12部分:微生物指标》
PART.2 水样采集
一、采样容器:洁净磨口硬质玻璃瓶;洁净聚乙烯瓶(桶或袋);也可以使用符合要求的一次性采样袋或采样瓶。
二、采样容器的洗涤
1. 容器洗涤:将容器用自来水和洗涤剂洗涤,并用自来水彻底冲洗后用质量分数为10%的硝酸(或盐酸)浸泡8h以上,然后依次用自来水和纯水洗净。
2. 容器灭菌:可采用干热或高压蒸汽灭菌两种。干热灭菌要求160℃下维持2h;高压蒸汽灭菌要求121℃下维持15min,高压蒸汽灭菌后的容器如不立即使用,应置于60℃烘箱内将瓶内冷凝水烘干。灭菌后的容器应在2周内使用。
三、采样要求
1. 无菌操作。
2. 不应用水样荡洗已灭菌的采样瓶或采样袋 。
3. 避免手指和其他物品对瓶口或袋口的玷污。
4. 自来水水样:先将水龙头用火焰烧灼3min灭菌再开放水龙头使水流5min(经常用水的水龙头放水1-3min)后,采集水样。
5. 水源水水样:选有代表性的地点及可疑地方,一般距水面下10-15cm采集,采样后在水中盖好盖子,再从水中取出。
6. 从速送检,在0~4℃下保存,水样从采集到检验不应超过8h。
PART.3.2 项目测定:总大肠菌群
一、概念
1. 一群在37℃培养,24h内能发酵乳糖、产酸产气、需氧和兼性厌氧的革兰氏阴性无芽孢杆菌。主要包括埃希氏菌属、柠檬酸细菌属、肠杆菌属、克雷伯氏菌属。
2. 饮用水中的总大肠菌群主要是指大肠杆菌、大肠菌群和粪大肠菌群三大类型细菌共同组成的大肠菌群。
二、意义
1. 总大肠菌群主要来自人和温血动物粪便,还可能来自植物和土壤。
2. 由于其数量大,在体外存活时间与肠道致病菌相似,且检验方法比较简便,故被作为检验肠道致病菌的指示菌。
3. 水中大肠菌群数的多少,表明水体被粪便污染的程度,并间接地表明有肠道传染病菌存在的可能性,但它不是专一的指示菌。
4. 如果在水样中检出总大肠菌群,则应再检验大肠埃希氏菌或耐热大肠菌群以证明水体是否已经受到粪便污染;如果水样中没有检出总大肠菌群,就不必再检验大肠埃希氏菌或耐热大肠菌群。
三、测定方法 —— 多管发酵法
1. 原理:经36℃±1℃培养24h,发酵乳糖产酸产气,经证实实验和革兰氏染色检测水中总大肠菌群的方法。
2. 培养液与培养基
2.1 乳糖蛋白胨培养液
成分:蛋白胨10g;牛肉膏3g;乳糖5g;氯化钠5g;溴甲酚紫乙醇溶液(16g/L)1mL;纯水1000mL(二倍浓缩乳糖蛋白胨培养液纯水500mL)。
制法:将蛋白胨、牛肉膏、乳糖及氯化钠溶于纯水中,调整pH为7.2~7.4,再加入1mL溴甲酚紫乙醇溶液,充分混匀。分装于装有小倒管的试管中,经115℃高压蒸汽灭菌20min后,于0~4℃冷藏避光保存。
2.2 伊红美蓝培养基
成分:蛋白胨10g;乳糖10g;磷酸氢二钾2g;琼脂20~30g;纯水1000mL;伊红水溶液(20g/L)20mL;美蓝水溶液(5g/L)13mL。
制法:将蛋白胨、磷酸盐和琼脂溶解于纯水中,校正pH为7.2,加入乳糖,混匀后分装,经115℃高压蒸汽灭菌20min。临用时加热融化琼脂,冷至50~55℃,加入伊红和美蓝水溶液,混匀,倾注平皿。
3. 实验步骤
乳糖发酵试验:
① 用无菌吸管或移液器吸取 10 mL水样接种到10 mL双料乳糖蛋白胨培养液中,取1 mL水样接种到10 mL单料乳糖蛋白胨培养液中,另取1 mL水样注入到9 mL无菌生理盐水中,混匀后取1 mL(即0.1 mL水样)注入到10 mL单料乳糖蛋白胨培养液中,每一稀释度接种5管;
② 对已处理过的出厂自来水,需经常检验或每天检验一次的,可直接接种5份 10mL水样接种10mL双料培养基,每份接种10 mL水样。
③ 检验水源水时,如污染较严重,应加大稀释度,可接种(1mL - 0.1mL - 0.01mL),甚至(0.1mL - 0.01mL - 0.001mL),每个稀释度接种5管单料乳糖蛋白胨培养液,每个水样共接种15管。接种1 mL以下水样时,应作10倍递增稀释后,取1 mL接种,每递增稀释一次,换用1支1mL无菌吸管。

④ 将接种管置于36 ℃±1℃培养箱内,培养24 h±2 h,如所有乳糖蛋白胨培养管都不产气产酸,则可报告为总大肠菌群未检出,如有产酸产气者,则按下列步骤进行。

分离培养:挑取符合下列特征的菌落进行革兰氏染色镜检
—— 深紫黑色、具有金属光泽的菌落;
—— 紫黑色、不带或略带金属光泽的菌落;
—— 淡紫红色、中心较深的菌落。
笔记:非典型菌落用不用革兰氏染色,挑几个菌落?标准里没有提到,这样会不会造成漏检?(个人觉得可疑菌落也要挑取验证的,GB8538里规定挑取10个典型菌落做验证,可以做参考)
证实试验:经上述染色镜检为革兰氏阴性无芽孢杆菌,同时接种乳糖蛋白胨培养液,置36 ℃±l℃培养箱中培养24 h±2 h,有产酸产气者,即证实有总大肠菌群存在。
4. 实验数据处理
结果报告:根据证实为总大肠菌群阳性的管数,查MNP表(根据GB/T5750.12所附检索表),报告每100mL水样中的总大肠菌群MNP值。稀释样品查表后所得结果应乘稀释倍数。如所有乳糖发酵管均为阴性时,可报告总大肠菌群未检出(报告与总则不一致,50mL水样报告100mL水样未检出不准确)。





5. 指标限值(总大肠菌群:不应检出MPN/100mL或CFU/100mL。)
四、其他
1. 如何杀灭饮用水中的总大肠菌群?
可通过化学消毒和煮沸杀灭饮用水中的总大肠菌群,常用的化学消毒剂是含氯制剂和二氧化氯,在日常生活中,煮沸是方便快捷的消毒方式,总大肠菌群在我省农村地区的饮用水中较为常见,因此提倡喝开水以降低和减少介水传染病的发生和流行。
2. 相关“大肠”菌
跟“大肠”有关的微生物学或卫生学名词有:总大肠菌群、大肠菌群、耐热大肠菌群、粪大肠菌群、大肠埃希氏菌、大肠杆菌、致病性大肠杆菌等等。
在上述名词中,除了“大肠杆菌”和“大肠埃希氏菌”是细菌学名词以外,其余几个都是卫生细菌领域用语,它不代表某一个或某一属细菌,而是指具有某些特性的一组细菌。
总大肠菌群=大肠菌群;耐热大肠菌群=粪大肠菌群(也有科学家认为耐热大肠菌群的范围大于粪大肠菌群);大肠埃希氏菌=大肠杆菌。
按范围大小排序:总大肠菌群(大肠菌群)>粪大肠菌群&耐热大肠菌群>大肠杆菌(大肠埃希氏菌)>致病菌。
大肠杆菌是人和温血动物肠道内普遍存在的细菌,是粪便中的主要菌种。一般生活在人大肠中并不致病,但它侵入人体一些部位时,可引起感染,且感染可能是致命的,尤其对老人和小孩!这些侵入人体部位能导致腹泻、呕吐等症状的,则称为致病性大肠杆菌。
说明:环凯转载于“ 食品微生物检测”公众号,内容版权属于归原作者所有(a萌记边学边记根据相关国标整理,编辑:食品小测,审核:小汇;);
提醒:文章、图片等所有内容,仅用于学习交流,若有侵权内容及其他涉法内容,请及时联系删除或修改。特此声明!







